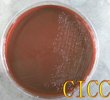

|
| |
| |
<tt id="8gymw"></tt>|
| |
|
|
|
|
|
|
|
|
 檢測認證人脈交流通訊錄
檢測認證人脈交流通訊錄
標準菌株
- 這真不是您需要的產品?
- 品 牌:
- 中國工業微生物菌種保藏管理中心 CICC
天堂中文在线网|
91精品国产闺蜜国产在线闺蜜|
在线天堂中文字幕|
99色精品视频|
久久av红桃一区二区禁漫|
午夜视频福利在线|
69视频免费看|
国产资源中文字幕|
免费 成 人 黄 色|
日本二区三区视频|
水蜜桃av无码|
免费看日韩av|
在线免费观看日韩视频|
亚洲精品国产91|
蜜臀av午夜精品|
日韩av免费播放|
久久精品www人人爽人人|
一区二区传媒有限公司|
a级黄色片免费看|
中文字幕一二三四区|
色呦呦免费观看|
国产一区二区三区成人|
黄色大片网站在线观看|
亚洲18在线看污www麻豆
|
在线观看17c|
麻豆av免费观看|
极品白嫩少妇无套内谢|
国产黄a三级三级三级|
国产女主播喷水视频在线观看|
日本中文字幕观看|
99999精品视频|
av在线com|
亚洲自拍偷拍一区二区三区|
亚洲色图 激情小说|
艳妇乳肉亭妇荡乳av|
日韩一卡二卡在线|
国产wwwxxx|
亚洲影视一区二区|
日韩精品一区二区亚洲av观看|
久久久香蕉视频|
欧美三级小视频|
国产一级片自拍|
男女视频在线看|
日本熟妇人妻中出|
乱妇乱女熟妇熟女网站|
99热亚洲精品|
欧美不卡在线播放|
成年人午夜免费视频|
日韩国产小视频|
youjizz.com在线观看|
大陆极品少妇内射aaaaaa|
午夜写真片福利电影网|
顶级黑人搡bbw搡bbbb搡|
天堂av网手机版|
国产午夜精品理论片|
夫妻性生活毛片|
www青青草原|
中文字幕在线有码|
www成人免费|
被灌满精子的波多野结衣|
久久人人爽人人爽人人av|
欧洲精品视频在线|
久久久久久人妻一区二区三区|
成人免费观看在线|
99精品在线免费视频|
无码人妻丰满熟妇区毛片18|
国产福利视频在线播放|
亚洲福利精品视频|
日本高清一区二区视频|
久久久99精品|
亚洲 欧美 中文字幕|
在线播放一级片|
www.五月天激情|
国内自拍偷拍视频|
久久国产精品无码一级毛片|
日本一道本视频|
一级黄色录像免费看|
aa视频在线播放|
一级特黄性色生活片|
欧美成人黄色网|
欧美亚洲另类小说|
亚洲国产精品久久久久久久|
欧美一级片在线免费观看|
性久久久久久久久久|
日本伦理一区二区三区|
大片在线观看网站免费收看|
精品无码一区二区三区在线|
www.夜夜爽|
99久在线精品99re8热|
亚洲午夜精品久久久|
日批视频在线播放|
日韩丰满少妇无码内射|
男人天堂成人网|
成年人小视频网站|
毛片a片免费观看|
,一级淫片a看免费|
中文字幕制服丝袜|
成年人一级黄色片|
日韩欧美在线播放视频|
久草精品视频在线观看|
国产又粗又猛又爽又黄的|
欧美熟妇另类久久久久久多毛|
精品欧美一区二区久久久|
久久99国产精品一区|
麻豆一区二区三区视频|
69视频免费在线观看|
亚洲伦理在线观看|
国产人妻大战黑人20p|
欧美一区二区视频在线播放|
特级黄色片视频|
影音先锋黄色网址|
性色av蜜臀av浪潮av老女人|
熟女视频一区二区三区|
孩娇小videos精品|
亚洲影视一区二区|
免费看黄色aaaaaa 片|
www.欧美黄色|
欧美黄色免费看|
国产高清在线免费|
少妇太紧太爽又黄又硬又爽小说|
浮妇高潮喷白浆视频|
日韩av电影网址|
天堂中文在线资源|
美女福利视频在线观看|
午夜啪啪小视频|
www.日韩高清|
91久久久久久久久久久久久久|
亚洲黄色a v|
一级片免费网站|
日本二区在线观看|
欧美在线观看视频网站|
在线观看免费视频a|
精品无码一区二区三区|
国产成人a亚洲精v品无码|
日韩黄色片网站|
右手影院亚洲欧美|
黄色免费福利视频|
中文字幕av无码一区二区三区|
成人一区二区三区仙踪林|
米仓穗香在线观看|
日本道在线观看|
久久精品无码专区|
黄色免费福利视频|
,一级淫片a看免费|
在线观看黄网址|
久久久久久久中文字幕|
男生和女生一起差差差视频|
日韩a级黄色片|
国产免费一级视频|
亚洲性猛交xxxx乱大交|
国产色视频在线播放|
超碰在线人人干|
ijzzijzzij亚洲大全|
99热国产在线观看|
谁有免费的黄色网址|
亚洲小视频网站|
黄色www视频|
男人添女人下部视频免费|
国产一区免费看|
99自拍偷拍视频|
日本一本高清视频|
国产全是老熟女太爽了|
青青草原播放器|
亚洲熟女乱综合一区二区|
337p粉嫩大胆噜噜噜鲁|
国产a级免费视频|
欧美中文字幕在线观看视频|
懂色av蜜臀av粉嫩av喷吹|
国产精品麻豆免费版现看视频|
国产一级片播放|
亚洲精品乱码久久久久久不卡|
亚洲黄色av网址|
日本女人黄色片|
在线免费观看视频黄|
91人妻一区二区三区|
久久九九国产视频|
亚洲少妇中文字幕|
亚洲第一天堂久久|
精品夜夜澡人妻无码av|
欧美xxxxxbbbbb|
欧洲av一区二区三区|
国产精品白浆一区二小说|
微拍福利一区二区|
天天操天天爽天天干|
182在线观看视频|
中文在线观看av|
欧美中日韩在线|
很污的网站在线观看|
99热在线只有精品|
国产九九九九九|
宇都宫紫苑在线播放|
成年网站在线播放|
99久久国产精|
日韩女优在线观看|
欧美色图亚洲视频|
国产免费黄色录像|
97xxxxx|
97中文字幕在线观看|
一级黄色在线播放|
手机毛片在线观看|
中文在线最新版天堂|
草b视频在线观看|
污视频网站在线播放|
无套内谢丰满少妇中文字幕
|
91久久免费视频|
日本特级黄色片|
国产青草视频在线观看|
蜜桃久久一区二区三区|
色婷婷一区二区三区av免费看|
国精产品一区二区三区|
无码人妻丰满熟妇区bbbbxxxx
|
无码人妻丰满熟妇区五十路|
第九区2中文字幕|
香蕉人妻av久久久久天天|
青青草成人免费|
国产av 一区二区三区|
亚洲黄色片视频|
日韩欧美理论片|
性欧美videos|
天堂av一区二区三区|
日韩欧美中文视频|
免费看av软件|
深爱五月激情五月|
国产精品7777|
欧美另类videos|
亚洲黄色小说在线观看|
久久久精品福利|
全黄性性激高免费视频|
久久久久久久久免费看无码|
性高潮视频在线观看|
青青草原av在线播放|
a级大片在线观看|
国产精品女同一区二区|
www.亚洲自拍|
91精品国产毛片武则天|
亚洲少妇一区二区三区|
亚洲综合图片网|
黄色aaa级片|
老熟妇高潮一区二区三区|
少妇人妻偷人精品一区二区
|
久久久久亚洲av无码专区
|
精品无码一区二区三区的天堂|
国模吧无码一区二区三区|
91激情视频在线观看|
www.五月天激情|
1级黄色大片儿|
黄色高清无遮挡|
四虎永久免费在线|
白嫩情侣偷拍呻吟刺激|
91麻豆成人精品国产免费网站|
国产大片一区二区三区|
人人妻人人澡人人爽欧美一区|
日韩精品卡通动漫网站|
亚洲黄色小说网|
在线观看污污网站|
国产aⅴ爽av久久久久|
日韩极品视频在线观看|
国产精久久一区二区三区|
三级网站免费看|
国产孕妇孕交大片孕|
日韩欧美亚洲一区二区三区|
激情综合网俺也去|
亚洲精品天堂成人片av在线播放|
少妇按摩一区二区三区|
五月婷婷六月丁香综合|
亚洲性生活大片|
午夜影院在线看|
天天影视色综合|
美女av免费在线观看|
中文字幕第50页|
你懂得视频在线观看|
国产一卡二卡三卡四卡|
二区三区在线视频|
国产一区二区三区在线观看|
精品美女久久久久|
日韩欧美中文视频|
91小视频网站|
成人综合视频在线|
91国在线高清视频|
中文字幕av播放|
成人午夜免费影院|
熟女俱乐部一区二区视频在线|
国产精品91av|
日本r级电影在线观看|
一级黄色片在线播放|
午夜视频网站在线观看|
国产午夜在线播放|
国产真实夫妇交换视频|
国产乱码一区二区三区四区|
欧美三级午夜理伦三级|
怡红院av亚洲一区二区三区h|
免费日韩在线观看|
99久re热视频精品98|
色中文字幕在线观看|
神马午夜精品91|
亚洲视频重口味|
欧美色图17p|
天天爽天天爽天天爽|
天堂网av2018|
精品人体无码一区二区三区|
久久视频精品在线观看|
波多野结衣av在线观看|
mm131美女视频|
av女人的天堂|
蜜臀久久99精品久久久久久|
91成年人网站|
天天干天天操天天拍|
天天干天天操天天拍|
日韩在线视频免费看|
国产67194|
在线观看18视频网站|
久久综合亚洲精品|
亚洲精品蜜桃久久久久久|
久激情内射婷内射蜜桃|
国产精品秘入口18禁麻豆免会员|
人妻少妇精品无码专区二区
|
激情 小说 亚洲 图片: 伦|
污污网站免费看|
污视频在线观看免费网站|
国产中文字字幕乱码无限|
91蜜桃视频在线观看|
日韩免费av网站|
国产精品国产一区二区三区四区|
国产特级黄色片|
天天操天天干天天操|
色婷婷精品久久二区二区密|
91精品人妻一区二区|
一级二级黄色片|
黄色网址在线免费看|
精品久久一二三|
三级在线视频观看|
久久免费视频精品|
国产又粗又猛又黄视频|
国产精品一区二区黑人巨大|
欧美亚洲精品在线观看|
白嫩情侣偷拍呻吟刺激
|
色噜噜日韩精品欧美一区二区|
国产又粗又猛又爽又黄的视频四季
|
久久噜噜色综合一区二区|
黄色影视在线观看|
日本中文字幕片|
久久精品www人人爽人人|
狠狠躁夜夜躁人人爽视频|
丰满少妇高潮在线观看|
亚洲观看黄色网|
中文字幕av免费在线观看|
1024av视频|
免费无遮挡无码永久在线观看视频|
亚洲精品中文字幕乱码三区91|
国产剧情久久久|
久久久老熟女一区二区三区91|
久久日免费视频|
成人在线观看你懂的|
伊人免费视频二|
最近中文字幕在线观看视频|
人妻与黑人一区二区三区|
中文精品在线观看|
黄色小视频大全|
日本中文字幕二区|
这里只有久久精品视频|
gogo亚洲国模私拍人体|
亚洲一级二级片|
日本女优爱爱视频|
久久夜色精品国产噜噜亚洲av|
亚洲精品免费在线观看视频|
国产免费无遮挡吸奶头视频|
www.avtt|
国产无遮挡又黄又爽又色|
精品人妻伦一二三区久久
|
成人性生交视频免费观看|
91激情在线观看|
朝桐光av一区二区三区|
蜜桃视频一区二区在线观看|
亚洲妇熟xx妇色黄蜜桃|
国产精品女人久久久|
jizz中文字幕|
成年人免费大片|
这里只有精品免费视频|
国产精品手机在线观看|
日本久久久网站|
www成人在线|
久久久久亚洲av无码网站|
中国 免费 av|
久久精品女人毛片国产|
亚洲三级在线视频|
可以在线看黄的网站|
日本一区二区三区四区五区|
亚洲欧美日韩动漫|
男人c女人视频|
国产情侣自拍av|
黄色av电影网站|
日韩人妻无码精品久久久不卡|
久久一区二区三区视频|
高清中文字幕mv的电影|
久久国产精品网|
欧美激情一区二区三区免费观看|
国产激情视频网站|
黄色一级一级片|
国产不卡精品视频|
91免费网站视频|
 檢測認證人脈交流通訊錄
檢測認證人脈交流通訊錄